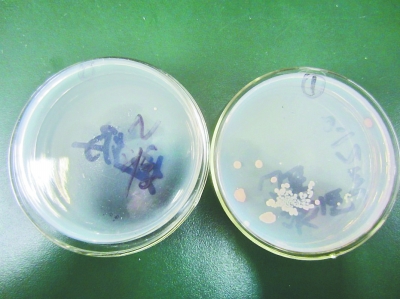

手机、鼠标比垃圾桶脏数十倍
专家提醒:常用物品定期清洁很重要

鼠标取样中
鼠标(右)与垃圾桶(左)细菌比较
记者魏娜
当下,手机、电脑等电子产品已成为大多人日常生活必需品。也许大家都知道,需要时时触碰的手机、电脑上“不太干净”,但到底有多脏呢?
近日,本期《生活实验室》邀请专业人员对随身携带的手机、平板电脑,以及办公室的电话机、鼠标、键盘表面的含菌量进行检测,并与室内家用垃圾桶作比。结果让人大吃一惊:这些我们经常触摸的电子产品,竟然比垃圾桶脏数十倍。
【实验地点】:武汉生物工程学院微生物学实验室
【实验人员】:武汉生物工程学院生物科技系讲师谢立兰
【实验名称】:手机、平板电脑、电话机、鼠标、键盘、垃圾桶清洁度比较
【实验材料】:随身携带的手机、平板电脑,办公室电话机、鼠标、键盘以及垃圾桶
(特别感谢武汉生物工程学院微生物学实验室、微生物应用技术协会对本次实验提供支持)
操作方法>>>
1、在无菌操作条件下,用蘸有无菌生理盐水的无菌棉签,在键盘——空格键、C键、V键、B键、N键和M键的表面及其间隙:鼠标——左右按键;手机和平板电脑——屏幕;垃圾桶——底部;电话机——拨号键等被测品表面反复涂拭3次。
2、剪去手接触部分后,将棉签放入含10mL无菌水的采样管内,将放有棉棒的试管充分振摇,以无菌操作取0.1ml样液至无菌平板中,涂布均匀后将平板置于37℃下培养18-24小时,计数菌落总数。
实验过程>>>
1、选择办公室中常用鼠标、键盘、电话机和垃圾桶,以及个人用的手机和平板电脑为对象,分别对其含菌量进行检测,比较不同用品的污染程度。所有检测对象均选择三份,以此做平行试验。
2、用75%酒精和专用清洗剂分别对鼠标和手机进行擦拭,在无菌操作区自然晾干,再次取样检测鼠标和手机擦拭后分别所含的总菌数,对比擦拭前后的微生物数量。所有检测对象均选择三份,以此做平行试验。
鼠标按键细菌数量是垃圾桶底的88倍
实验结果>>>
通过实验,我们可以看到,在被检的样品中,鼠标按键的单位面积含菌量高达1332个/平方厘米,污染最严重,键盘和电话机按键次之;而手机屏幕每平方厘米的含菌量也达到323个,是垃圾桶的21倍。
手机、平板电脑、电话机、键盘、鼠标以及垃圾桶上存在的细菌数量(个/平方厘米):手机:323;平板电脑:38;电话机:776;键盘:826;鼠标:1332;垃圾桶:15。(特别说明:由于手机和鼠标等检测样品的污染情况,还受个人使用习惯和保养影响,同时由于检测样本数量有限,本次测试数据仅对本次检测物品有效。)
擦一下,手机上的细菌数减少85%以上
使用75%的酒精和屏幕专用清洁剂,分别对手机屏幕和鼠标进行了清洁后,手机和鼠标上的细菌数减少了85%以上。这说明保洁作用明显。
征集令
生活有科学,实验揭真相。本报新闻栏目《生活实验室》,栏目立足“实验”二字,以数据说话,用事实证明。如果,你在生活中遇到疑惑,或有稀奇古怪的念头,或有惊奇的生活小发现,想请科研人员用科学的方式方法来证明,就可以告诉我们。如果你本身就是“实验控”,自己通过实验有生活发现或发明,想“公告天下”,我们也可以为你做到。如果,你是某方面的行家、专家(“砖家”?也行!只要有所擅长都行!),或者动手能力强,欢迎加入我们的实验队伍,一起成为“生活实验党”,见证用科学揭开真相的那一刻。尤其欢迎科研院所、大专院校、中学师生以及专业公司的技术人员。参与实验者,有小惊喜喔。
实验室热线:13098828992
电子邮件: shiyan2049@126.com
新浪微博: @武汉生活实验室
电子产品带菌会引发 流感、结膜炎、腹泻
记者魏娜 通讯员闫鹿
“很多人认为自己经常使用的物品应该不脏,而家里或者办公室环境卫生也不错,常用物品也不必经常清洁,其实不然。”武汉生物工程学院生物科技系老师谢立兰说,实验数据显示这些随身物品比想象中还要脏,应该定期进行清洁。
手机屏幕细菌可引发多种疾病
“打电话时,手机需要与手、耳朵、鼻子和嘴亲密接触,这时手机会发热,其温度也恰好是细菌所喜欢的。”武汉大学中南医院呼吸内科专家表示,一些我们以为很私人化的东西实际上对公众所造成影响比我们想象中要大。一部手机上的病菌有可能引发流感、传染性结膜炎或者腹泻。
手上的皮肤有纹路携带病菌的机会很多,同时人体的各种体液也会因接触而残留在这些常用物品之上,自然增加了病菌滋生的机会,定期对常用物品进行清洁,不仅可以增加我们使用的舒适感,也使沾染病菌引发疾病的机会大大减少。
人们都知道饭前便后要洗手,甚至在倒了垃圾后,也会及时洗手,但很少人会在触碰手机、平板电脑或者在办公室打了电话后,养成洗手的习惯。
2011年美国《应用微生物学期刊》上发表的一项研究报告警告称,大约20%到30%的病菌能够轻易地从指尖传到玻璃表面,比如手机触屏上。
选对清洁剂擦拭电子产品
清洁电子产品时,可使用75%的医用酒精,也可以借助一些适合的专业清洁剂,这样在保持物品清洁卫生的同时也能起到保养维护的作用。
谢立兰说,因为生活中也有很多人经常对常用物品和家用电器进行清洁,却很少注意清洁方法。或者是用沾水的抹布直接清洁,或者是用各种消毒剂直接清洁。
需要提醒大家的是,清洁各类常用物品和家用电器需要根据材料特性选择适合的清洁剂与清洁方法,同时要认真了解所用清洁剂的化学特性。
比如清洁家用电器通常采用潮湿的软质抹布,而在类似手机、电脑屏幕等物品的清洁中若打算使用清洁剂一定要根据说明书选择专用清洁剂,不使用有机溶剂,从而避免操作不当造成损失。

详细链接:http://cjrb.cjn.cn/html/2013-11/01/content_5244704.htm